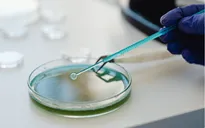
Bộ Y tế yêu cầu xử lý vụ nghi ngộ độc thực phẩm do ăn cá ủ chua tại Đà Nẵng

Ảnh minh họa: Getty Images
Gần đây, một ca nghi ngờ ngộ độc botulinum đã được ghi nhận tại Đà Nẵng.
Các triệu chứng phổ biến bao gồm: mệt mỏi, suy nhược, chóng mặt (mất thăng bằng), thường đi kèm với là mờ mắt, khô miệng, khó nuốt và nói, cùng với các triệu chứng nghiêm trọng hơn.
Để giảm nguy cơ mắc bệnh này, Tổ chức Y tế thế giới (WHO) tại Việt Nam khuyến cáo cộng đồng hãy thực hành chế biến và tiêu thụ thực phẩm đúng cách.
Và để bảo vệ bản thân khỏi ngộ độc thực phẩm nói chung, WHO chia sẻ 5 chìa khóa an toàn thực phẩm, bao gồm:
- Giữ tay và các bề mặt sạch sẽ;
- Bảo quản riêng biệt thức ăn sống và chín;
- Nấu kỹ thức ăn;
- Bảo quản thực phẩm ở nhiệt độ phù hợp;
- Sử dụng nước sạch và thực phẩm tươi sống.
Đồng thời, WHO cung cấp thông tin hữu ích để phòng ngừa ngộ độc botulinum như sau:

Bình luận (0)